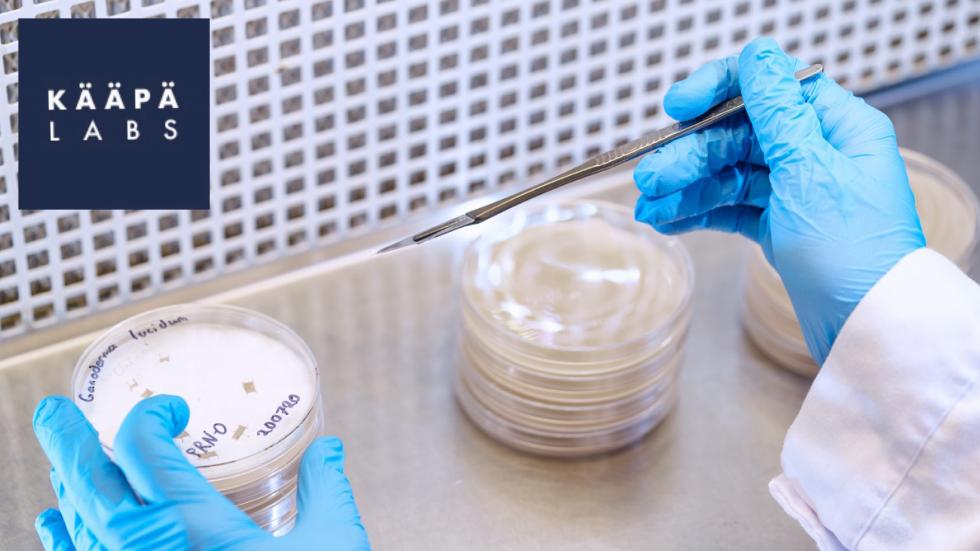
KÄÄPÄ Labs

KÄÄPÄ Biotech is a Finnish-based biotechnology company with expertise in scalable, novel fungal applications for taking a wide-range of mycological solutions to market.

SKILLS & KNOWLEDGE in large-scale basidio/ascomycete fungi culturing (spore or wild isolate - to -sporocarp), growth conditions and media optimisation (solid and liquid mediums), fungal extractions for bioactive-enriched consumer products (including ultrasonic assisted extraction or UAE) and beta-glucan testing, biodiversity conservation of rare and endangered fungal species (culturing and inoculation), sustainable forest management solutions regarding fungal inoculations (mycorrhizal and wood-decay in live, dead, and waste wood), fungal delivery mechanisms (inoculation tools), fungal-optimising of functioning bio/physical/chemical properties of soils, rhizosphere or lignocellulosic-based materials, funding-call applications, industry pitches and investigatory scientific writing.
DESIRABLE PARTNERS complementary research institutes or parties, complimentary SMEs for circular practices, conservation and biodiversity protection policy/legal experts, novel chitinous or other fungal bioactive constituent prospectors.
Contact us